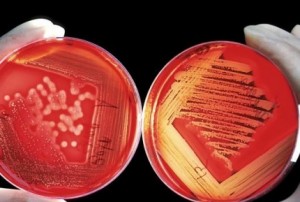

-
Nuevas recomendaciones para los tratamientos contra el ébola
19 de agosto de 2022 -
La mitad de las muertes por cáncer se deben a factores de riesgo previsibles
19 de agosto de 2022 -
Repararon a nuevo la terapia intermedia pediátrica del Hospital Evita de Lanús
19 de agosto de 2022 -
Mañana entra en vigencia la Ley de Promoción de la Alimentación Saludable
19 de agosto de 2022 -
La pérdida auditiva afecta a 1,500 millones de personas indica la OMS
18 de agosto de 2022 -
La COFA recibió un reconocimiento de la Academia Nacional de Farmacia y Bioquímica
18 de agosto de 2022 -
Rodríguez Larreta inauguró el tomógrafo del Hospital Álvarez
18 de agosto de 2022 -
Proyecto para fortalecer al sector de salud en acciones de mitigación y adaptación al cambio climático
18 de agosto de 2022 -
Aseguran que la tecnología Flash de monitoreo de glucosa mejora el control de la diabetes
18 de agosto de 2022 -
El 70% de los niños entre 0 y 7 años tiene otitis durante el invierno
17 de agosto de 2022 -
Monkeypox: los expertos dan nuevos nombres a las variantes del virus
17 de agosto de 2022 -
Lograron modificar el tipo de sangre de riñones de donantes para trasplante
17 de agosto de 2022